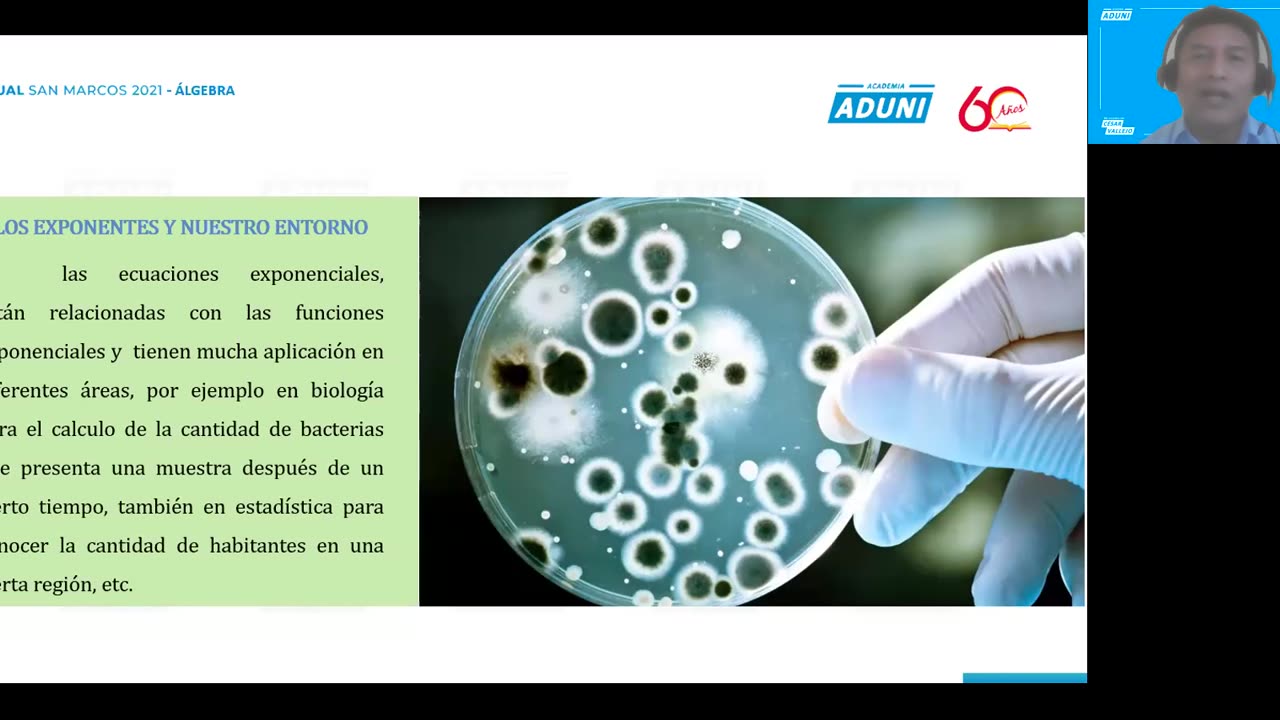
ANUAL ADUNI 2021 | Semana 04 | Álgebra

Premium Only Content
This video is only available to Rumble Premium subscribers. Subscribe to
enjoy exclusive content and ad-free viewing.
ANUAL ADUNI 2021 | Semana 04 | Álgebra
4 hours ago
11
Conviértete en un eslabón clave en esta cadena de apoyo 🔗. Comparte este canal 📲 en todas tus redes sociales: https://bit.ly/Loganx_Maths
¡NO TE LO GUARDES! 🤫
Únete al grupo de FB: https://bit.ly/FBLoganMaths
No te olvides dejar tu terrible like 🙃
If you liked this video, don't forget to subscribe to my channel, like it and share it with your friends. Leave me your questions in the comments!
- ALGEBRA - ARITHMETIC - GEOMETRY - TRIGONOMETRY - RAZ. MATHEMATICS - MATHEMATICAL SKILL - RAZ. VERBAL - VERBAL SKILL - CHEMISTRY - PHYSICS - PRE PROBLEMS - CEPRE UNI - PRE SAN MARCOS - CEPREVI - UNALM - ADUNI ACADEMY - VALLEJO ACADEMY - TRILCE - PITÁGORAS
Loading comments...
-
 26:11
26:11
Athlete & Artist Show
15 hours agoWho Will Make Team Canada + Finland IIHF Controversy
2.57K1 -
 3:38
3:38
Blackstone Griddles
15 hours agoBlackstone Betty's Avocado Toast on the Blackstone Griddle
4771 -
 23:17
23:17
Fit'n Fire
19 hours ago $0.43 earnedShould You Own A Budget Rifle? PSA Freedom 15 vs Hi-Point HP15 vs Kel-Tec RDB
3.43K5 -
 8:26
8:26
Hollywood Exposed
15 hours agoKid Rock LEAVES Bill Maher Scrambling After Trump Debate Gets Messy
4.74K4 -
 LIVE
LIVE
BEK TV
2 days agoTrent Loos in the Morning - 11/17/2025
163 watching -
 9:25
9:25
MattMorseTV
15 hours ago $28.11 earnedTrump’s GAMBLE just PAID OFF… BIG TIME.
49.5K90 -
 18:03
18:03
Nikko Ortiz
20 hours agoNikko Ortiz Night Routine...
105K17 -
 LIVE
LIVE
FyrBorne
10 hours ago🔴Battlefield REDSEC Live M&K Gameplay: Pyro+ Games
210 watching -
 LIVE
LIVE
Lofi Girl
3 years agolofi hip hop radio 📚 - beats to relax/study to
397 watching -
 2:12:56
2:12:56
BBQPenguin_
2 hours agoEscape From Tarkov 1.0 Wipe! New Story & Full Release!
4.62K